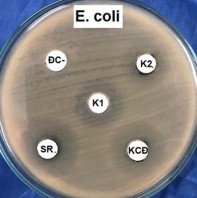
Hình 4 4 Hoạt tính ức chế E coli và S aureus của cây Sói rừng và cây Khoan cân 1
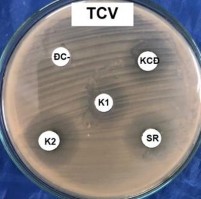
Hình 4 4 Hoạt tính ức chế E coli và S aureus của cây Sói rừng và cây Khoan cân 2

4
Nữ
Nam
0
1
2
Số người điều tra được
3
4
Nhóm tuổi
25-49
50-75
Kết quả Bảng 4.14 cho thấy, tại KVNC số thầy lang tập trung chủ yếu ở cộng đồng dân tộc Nùng, chiếm 50,00% so với tổng số thầy lang, bà mé đã điều tra được, bởi lễ dân tộc Nùng chiếm số lượng nhiều hơn là bởi vì dân tộc Nùng là dân tộc chiếm phần lớn các dân tộc ở khu vực nghiêm cứu, là dân tộc đã cư trú từ lâu đời nên vấn đề truyền thụ kiến thức phòng chữa bệnh được truyền tải tốt hơn. Còn dân tộc Tày và Dao chỉ chiếm 25,00% so với tổng số thầy lang bà mé được điều tra.
2 | |
0 | |
2 | |
Có thể bạn quan tâm!
-
Số Lượng Họ, Chi, Loài Thuộc 2 Lớp Trong Ngành Ngọc Lan -
Sự Phân Bố Nguồn Cây Thuốc Theo Môi Trường Sống Ở Kvnc -
Tỷ Lệ Nhóm Bệnh Chữa Trị Từ Nguồn Cây Thuốc Theo Kinh Nghiệm Sử Dụng Trong Cộng Đồng Dân Tộc Tày, Nùng, Dao Tại Xã Lê Lai -
Nghiên cứu tri thức bản địa sử dụng cây thuốc tại xã Lê Lai, huyện Thạch An, tỉnh Cao Bằng - 9 -
Nghiên cứu tri thức bản địa sử dụng cây thuốc tại xã Lê Lai, huyện Thạch An, tỉnh Cao Bằng - 10 -
Nghiên cứu tri thức bản địa sử dụng cây thuốc tại xã Lê Lai, huyện Thạch An, tỉnh Cao Bằng - 11
Xem toàn bộ 96 trang tài liệu này.
Hình 4.3. Tỷ lệ về độ tuổi của các thầy thuốc ở KVNC
Kết quả nghiên cứu ở Hình 4.4 cho thấy, người làm nghề thầy thuốc ở Khu vực nghiên cứu chủ yếu là người nam giới và thuộc độ tuổi 50 -75 nghề làm thầy lang chủ yếu là nam giới và thuộc nhóm tuổi từ 50-75 tuổi. Điều này dễ giải thích theo truyền thống nghề này đa số được truyền thụ theo huyết thống gia đình, nếu khi bố mẹ còn sống họ sẽ giữ vai trò chính trong việc bốc thuốc và dạy lại cho con cái mình qua quá trình tích lũy dần dần. Khi bố mẹ già yếu không thể tiếp tục làm nghề nữa mới chính thức truyền lại cho con cái, lúc đó độ tuổi thông thường của con cái họ giao động khoảng 40 tuổi. Sau một số năm kinh nghiệm làm nghề thì độ tuổi của các ông lang bà mế nhiều nhất là khoảng 50 - 75 tuổi.
Nhóm tuổi từ 25 – 49 thì đây được coi nhóm người lao động chính trong gia đình, họ thường tập trung vào trong lao động sản xuất, chăn nuôi, kinh doanh để đáp ứng nhu cầu cuộc sống gia đình họ, do vậy họ hầu như chưa có thời gian được tiếp thu những bài thuốc từ những người lớn tuổi, do đó trong quá trình điều tra nghiên cứu chỉ có 2 người có độ tuổi từ 25 – 49 có kiến thức trong việc sử dụng các loài cây thuốc để phòng và chữa bệnh, chiếm 25,00% và cả 2 người đều la dân tộc Nùng. Chúng ta có thể thấy những người trẻ dưới 25 tuổi hầu như không tham gia vào việc thu thập cây thuốc, điều này có thể lí giải là ở độ tuổi này chủ yếu là độ tuổi còn đang đi học, tham gia các hoạt động xã hội, chưa tích lũy được nhiều kinh nghiệm, vốn sống và những kiến thức bản địa của ông cha truyền lại.
Tóm lại, những thầy lang có kinh nghiệm trong việc sử dụng các loài cây thuốc chủ yếu tập trung độ tuổi từ 50 trở lên. Do đó, việc phát giữ gìn và tiếp thu những giá trị truyền thống tốt đẹp đó là hết sức cần thiết.
4.4. Đánh giá hoạt tính kháng khuẩn của một số loài cây thuốc được sử dụng trong cộng đồng các dân tộc thiểu số ở khu vực nghiên cứu
Từ kết quả nghiên cứu kinh nghiệm sử dụng cây thuốc của cộng đồng một số dân tộc ở khu vực nghiên cứu trong việc phòng và điều trị một số bệnh nhiễm khuẩn, tôi tiến hành lựa chọn cây Sói rừng - Sarcandra glabra (Thunb.) Nakai và cây Khoan cân đằng - Tinospora sinensis (Lour.) Merr để tiến hành đánh giá hoạt tính kháng khuẩn (HTKK) của cây. Kết quả thể hiện ở Bảng 4.15 và Hình 4.3.
Bảng 4.15. Hoạt tính kháng khuẩn của cao chiết từ cây Sói rừng và cây Khoan cân đằng
Đơn vị tính: mm
Sói rừng (SR) | Khoan cân đằng (KCĐ) | Đối chứng dương – K1 (Amikacin) | Đối chứng dương – K2 (Kanamicin) | Đối chứng âm (Dung môi) | |
S. aureus | 21,1±0,3 | 20,5±0,7 | 19,2±1,2 | 24,3±1,1 | 0 |
E. coli | 24,2±0,5 | 23,7±0,8 | 21±0,5 | 20,2±0,9 | 0 |
Qua dữ liệu trên cho thấy, hai loài khảo sát (Sói rừng và Khoan cân đằng) đều có hoạt tính ức chế đối với vi khuẩn gây bệnh. Cả 2 loài Sói rừng và Khoan cân đằng đều có hoạt tính cao ức chế với cả 2 vi khuẩn gây bệnh Gram dương (S. Aureus) và Gram âm (E. coli) với vòng ức chế đạt được với loài Sói rừng là 21,1 mm với vi khuẩn Gram dương (S. aureus) và 24,2 mm với vi khuẩn Gram âm (E. Coli). Trương tự với cây Khoan cân đằng là 20,5 mm với vi khuẩn Gram dương (S. aureus) và 23,7 mm với vi khuẩn Gram âm (E. Coli).
So sánh giữa 2 loài cho thấy loài Sói rừng có hoạt tính kháng khuẩn mạnh hơn loài Khoan cân đằng. Cả 2 loài này có hoạt tính kháng khuẩn khá mạnh, và cao hơn so với kháng sinh Amikacin ở cả 2 thí nghiệm thử 2 chủng vi khuẩn Gram dương – Gram âm, và cao hơn so với kháng sinh Kanamicin ở thí nghiệm thử với chủng vi khuẩn Gram âm. So với đối chứng âm (dung môi) thì cả 2 loài cây mẫu đều có tính kháng khuẩn, ngược lại đối chứng âm (dung môi) không có tính kháng khuẩn đối với 2 vi khuẩn gây bệnh Gram dương (S. Aureus) và Gram âm (E. coli).
Từ kết quả phân tích hoạt tính kháng khuẩn tôi đề xuất, có thể sử dụng cây Sói rừng và Khoan cân đằng để phòng ngừa và kiểm soát một số bệnh nhiễm khuẩn do S. aureus (Tụ cầu vàng) và E. coli gây ra. Kết quả này là một bằng chứng khoa học chứng minh kinh nghiệm sử dụng các cây thuốc này trong
việc phòng chống một số bệnh nhiễm khuẩn của cộng đồng các dân tộc thiểu số ở xã Lê Lai, huyện Thạch An, tỉnh Cao Bằng.
|
Hình 4.4. Hoạt tính ức chế E. coli và S. aureus của cây Sói rừng và cây Khoan cân đằng
Chú thích: TVC: Staphylococus aureus; E. coli: Escherichia coli; ĐC: Đối chứng âm (Dung môi); K1: Đối chứng dương (Amikacin); K2: Đối chứng dương (Kanamicin); SR: Sói rừng; KCĐ: Khoan cân đằng
5.1. Kết luận
PHẦN 5
KẾT LUẬN – KIẾN NGHỊ
Quá trình điều tra, nghiên cứu tri thức bản địa sử dụng cây thuốc tại xã Lê Lai huyện Thạch An, tỉnh Cao Bằng, chúng tôi đã thu được những kết quả như sau:
- Quá trình điều tra nghiên cứu đã điều tra được 107 loài thực vật bậc cao có mạch, thuộc 102 chi và 70 họ, trong ngành ngọc lan chiến ưu thế nhất với 100 loài thuộc 95 chi và 64 họ. Có 8 họ nhiều loài nhất, trong đó họ cúc (Asteraceae) có 8 loài, họ Dâu tằm (Moraceae) có 6 loài, họ thầu dầu (Euphorbiaceae) có 4 loài còn lại là 3 loài. Trong 102 chi có 2 chi nhiều loài nhất là chi Ficus và chi Smilax.
- Đề tài xác định 7 dạng sống trong đó dạng sống là thân thảo được sử dụng nhiều nhất với 39 loài, bụi 26 loài, dây leo 22 loài, gỗ nhỏ và gỗ trung bình 7 loài, gỗ lớn 4 loài, kí sinh và bán kí sinh 2 loài.
- Đã tìm hiểu được môi trường sống chủ yếu của các loài cây thuốc là ở rừng với 79 loài, ở vườn làng xóm 44 loài, ven sông 14 loài và đồi cây bụi, trảng cỏ là 9 loài.
-Đã thống kê được 11 loài cần bảo tồn, trong đó có 6 loài có tên trong sách đỏ Việt Nam 2007, 8 loài có tên trong Nghị Định 06/2019/NĐ – CP và 5 loài có tên trong Danh lục đỏ cây thuốc Việt Nam 2006
- Đã xác định được có 9 bộ phận khác nhau được sử dụng theo kinh nghiệm của các cộng đồng dân tộc Tày, Nùng, Dao tại xã Xã Lê Lai, trong đó bộ phận cả cây, lá, củ, rễ là 4 bộ phận có tần số được sử dụng nhiều nhất trong chữa trị bệnh cho người dân nơi đây.
- Đã thống kê được 16 nhóm bệnh khác nhau được chữa trị bằng kinh nghiệm sử dụng cây thuốc trong cộng đồng dân tộc Tày, Nùng, Dao tại khu vực
nghiên cứu. Trong đó số lượng cây thuốc được sử dụng để chữa trị tập trung phần lớp vào các nhóm bệnh là: Nhóm làm thuốc bổ; bệnh về xương khớp, hệ vận động; bệnh về tiêu hóa; bệnh về đường tiết niệu; bệnh ngoài da; và nhóm bệnh hô hấp.
- Qua kết quả điều tra về kinh nghiệm sử dụng cây thuốc của 3 cộng đồng Nùng, Tày và Dao đã xác định được có 5 loài cây cỏ được cả 3 cộng đồng dùng trong phòng và chữa bệnh đó là các loài Bảy lá một hoa - Paris chinensis Franch; tắc kè đá - Drynaria bonii Christ; Giảo cổ lam - Gynostemma pentaphyllum (Thunb.) Makino; …
- Qua kết quả phân tích hoạt tính kháng khuẩn, cho thấy có thể sử dụng cây Sói rừng và Khoan cân đằng để phòng ngừa và kiểm soát một số bệnh nhiễm khuẩn do S. aureus (Tụ cầu vàng) và kiểm soát một số bệnh nhiễm khuẩn do E. coli gây ra.
5.2. Kiến nghị
- Cần tiếp tục mở rộng khu vực điều tra và nghiên cứu về tài nguyên cây thuốc để có kế hoạch bảo tồn và phát triển nguồn dược liệu cho tương lai.
- Tiếp tục nghiên cứu và đánh giá tính hiệu quả của các loài cây thuốc mà cộng đồng dân tộc tại xã Lê Lai, huyện Thạch An, tỉnh Cao Bằng sử dụng.
- Xây dựng những vườn thuốc trong gia đình cho những gia đình lương y hay những gia đình có những người biết sử dụng thuốc ở các thôn bản để bảo vệ nguồn gen quý và hướng dẫn cách trồng hái, chế biến cho phù hợp.
- Với những loài cây thuốc thuộc dạng quý hiếm cần hướng dẫn nhân dân nhận biết và tiến hành bảo vệ rừng, hạn chế khai thác một cách cạn kiệt các loài cây thuốc để bán sang Trung Quốc.
TÀI LIỆU THAM KHẢO
A. Tiếng việt
1. Đỗ Huy Bích (2004), Cây thuốc và động vật làm thuốc ở Việt Nam, Nxb
2. Hờ A Bình (2019) “Nghiên cứu về đa dạng tài nguyên cây thuốc của người Hmong, huyện Mù Cang Chải, tỉnh Yên Bái”, Khóa luận tốt nghiệp Đại học Trường Đại học Nông Lâm Thái Nguyên.
3. Bộ Khoa học và Công nghệ (2007), Sách đỏ Việt Nam, phần Thực vật. Nxb Khoa học Tự nhiên và Công nghệ.
4. Tào Duy Cần (2001), Thuốc Nam, thuốc Bắc và các phương thang chữa bệnh, Nxb Khoa học và Kỹ Thuật.
5. Tào Duy Cần (2006), Thuốc bệnh 24 chuyên khoa, Nxb Y học.
6. Đặng Quang Châu (2011), “Một số dẫn liệu về cây thuốc của dân tộc Thái ở huyện Nghĩa Đàn – Nghệ An”. Tạp chí Sinh học, tập 23.
7. Đặng Quang Châu, Bùi Hồng Hải (2003), “Điều tra cây thuốc của đồng bào dân tộc Thái, xã Xuân Hạnh, huyện Quỳ Châu – Nghệ An”, Báo cáo Khoa học Hội nghị toàn quốc lần 2. Những vấn đề nghiên cứu cơ bản trong Khoa học Sự sống, Nxb Khoa học và Kỹ Thuật, Hà Nội.
8. Vò Văn Chi (1996), Từ điển cây thuốc Việt Nam, Nxb Y học, Hà Nội.
9. Vò Văn Chi (2012), Từ điển cây thuốc Việt Nam, Nxb Hà Nội, tập 1-2.
10. Chính phủ nước cộng hòa xã hội chủ nghĩa Việt Nam (2019), Nghị định 06/2019/NĐ-CP về nghiêm cấm, hạn chế khai thác và sử dụng các loài động thực vật hoang dã.
11. Vũ Văn Chuyên (1976), Tóm tắt đặc điểm các họ cây thuốc, Nxb Y học Hà Nội.
12. Lưu Đàm Cư, Hà Tuấn Anh, Trương Anh Thư (2004), “Các cây có ích của dân tộc H’mông và khả năng ứng dụng trong phát triển kinh tế”, Báo cáo Khoa học Hội nghị toàn quốc lần 3. Những vấn đề nghiên cứu cơ bản trong Khoa học Sự sống, Thái Nguyên, Nxb Khoa học và Kỹ Thuật, Hà Nội.
13. Nguyễn Thượng Dong (2006), “Nghiên cứu thuốc từ thảo dược” (Giáo Trình sau đại học). Nxb Khoa học và Kỹ Thuật, Hà Nội.
14. Lê Trần Đức (1997), Cây thuốc Việt Nam, trồng hái chế biến và trị bệnh ban đầu. Nxb Nông nghiệp, Hà Nội.
15. Nông Thu Hằng (2019) “Nghiên cứu kiến thức bản địa về khai thác và sử dụng một số cây dược liệu (lâm sản ngoài gỗ) tại vườn quốc gia Phia Oắc- Phia Đén, huyện Nguyên Bình, tỉnh Cao Bằng”, Khóa luận tốt nghiệp Đại học, Trường Đại học Nông Lâm Thái Nguyên.
16. Nguyễn Minh Hiếu (2019) “Nghiên cứu tri thức bản địa sử dụng cây thuốc tại xã Nặm Pung, huyện Bát Xát, tỉnh Lào Cai của đồng bào dân tộc Dao”, Khóa luận tốt nghiệp Đại học, Trường Đại học Nông Lâm Thái Nguyên.
17. Phạm Hoàng Hộ (1999 – 2000), Cây cỏ Việt Nam, Nxb trẻ, Tp Hồ Chí Minh. Tập 1 – 3.
18. Phạm Hoàng Hộ (2000), "Cây cỏ Việt Nam”, Nhà xuất bản trẻ, Tp. Hồ Chí Minh
19. Nông Thái Hòa (2018) “Nghiên cứu cây thuốc và đánh giá hoạt tính kháng khuẩn của một số loài cây thuốc tại xã Hoàng Nông, huyện Đại Từ, tỉnh Thái Nguyên”, Khóa luận tốt nghiệp Đại học, Trường Đại học Nông Lâm Thái Nguyên.
20. Dương Văn Hưng (2018) “Nghiên cứu tri thức sử dụng cây thuốc tại xã Yên Ninh, huyện Phú Lương, tỉnh Thái Nguyên”, Khóa luận tốt nghiệp Đại học, Trường Đại học Nông Lâm Thái Nguyên.
21. Âu Anh Khâm (2001), 577 bài thuốc dân gian gia truyền (sách dịch), Nxb Thanh niên.
22. Quàng Văn Kiêm (2019), “Nghiên cứu tri thức bản địa sử dụng cây thuốc tại xã Kim Đồng, huyện Thạnh An, tỉnh Cao Bằng”, Khóa luận tốt nghiệp Đại học, Trường Đại học Nông lâm Thái Nguyên.
23. Vàng A Lả (2018) “Nghiên cứu cây thuốc và đánh giá hoạt tính kháng khuẩn của một số loài cây thuốc tại xã Yên Lạc, huyện Phú Lương, tỉnh